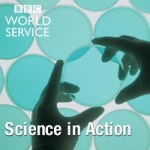
BBC Science in Action

Podcasts are great, they provide a lot of great information to the listener. Depending on what you listen to, there is always something available for everyone. I’ve recently really got into listening to them, from science based ones to others which tickle my fancy.
Science-based podcasts are amazing, they provide me with information on the latest information regarding scientific discoveries to bleeding-edge work on the work I’m interested into.
Here I’ll be listing a few that I listen to, or have recently discovered and find to be amazing worth sharing.
BBC Inside Science
 I have actually been listening to BBC Inside Science for a while now, Dr Adam Rutherford and guests are amazing at telling the listeners all the latest mysteries, challenges and controversies that surrounds science that’s changing in our world. Every episode is around 30 minutes, which is fully packed with information that the listeners cares about. If you are into science, and the latest information that surrounds the world of science, then you will definitely like this podcast.
I have actually been listening to BBC Inside Science for a while now, Dr Adam Rutherford and guests are amazing at telling the listeners all the latest mysteries, challenges and controversies that surrounds science that’s changing in our world. Every episode is around 30 minutes, which is fully packed with information that the listeners cares about. If you are into science, and the latest information that surrounds the world of science, then you will definitely like this podcast.
BBC Inside Science’s latest episode covers “Genetics and education, Eyam plague, Pint of science, Labradors and chocolate”, if you’d like to listen to it, go ahead by clicking here.
The Science Hour
 The Science Hour by the BBC is another great example of a podcast which highlights science, health and technology news of the week. If you are like me, then getting a curated piece of information right in front of you is something that is great, this podcast does this. Like the Inside Science above, this is a weekly podcast which is a great example which I listen to very often.
The Science Hour by the BBC is another great example of a podcast which highlights science, health and technology news of the week. If you are like me, then getting a curated piece of information right in front of you is something that is great, this podcast does this. Like the Inside Science above, this is a weekly podcast which is a great example which I listen to very often.
Science Hour has a large number of episodes, it’s latest episode covers “Genetics and Educational Attainment”, if you’d like to listen to it, click here.
Science in Action
 Another from the BBC see’s Roland Pease and guests discussing the latest science research and news stories from all over the world. Many of the episodes are rich and packed with information about all things science. Science In Action covers all the recent outbreaks and news, such as the Zika Virus and so on. Science In Action, like many other podcasts, tries it’s best to keep on track with the latest science as well as bringing in a range of great guests.
Another from the BBC see’s Roland Pease and guests discussing the latest science research and news stories from all over the world. Many of the episodes are rich and packed with information about all things science. Science In Action covers all the recent outbreaks and news, such as the Zika Virus and so on. Science In Action, like many other podcasts, tries it’s best to keep on track with the latest science as well as bringing in a range of great guests.
Science In Action covers a vast variety of topics, it’s latest podcast episode covers “Arctic Warming Could Be Changing Bird’s Shape”, which can be listened here.
These three podcasts from the BBC will usually cover all that I require, but there are many more different types of podcasts which covers many different topics. For example, Niel deGrasse Tyson’s StarTalk Radio covers all things about science, comedy and pop culture. Discovery from the BBC World Service covers the world of science in half-hour episodes too.
Another is the BBC Radio 4’s The Infinite Monkey Cage which is run by Brian Cox and Robin Ince in a witty, irreverent look at the world through scientists’ eyes. The Guardian’s Science Weekly is another fantastic podcast which covers everything with analysis and interviews from individuals in science and technology.
One which I have heard quite a lot about is Nature Podcast. If you are a scientist, then you must have heard of Nature, one of the biggest and long running journals covering everything from astronomy to neuroscience. I’ve not had the pleasure of listening to the episodes, but it’s on my que to listen to.
Similar to Nature Podcast, I’ve also not had the chance to listen to a couple but have heard a lot of good things about them. This includes, TEDTalks Science and Medicine, which discusses everything in these topics. Science Friday (SciFri) covers everything from outer space to the tiniest of microbes.
With such an extensive list of amazing podcasts to listen to, it can take some time to listen to them all. I use the app PocketCasts which is available on the web, Android devices and Apple devices. If you have a favourite podcast that you listen to, or one that I’ve mentioned and you’d like to talk about. Go on, comment down below and let’s talk.